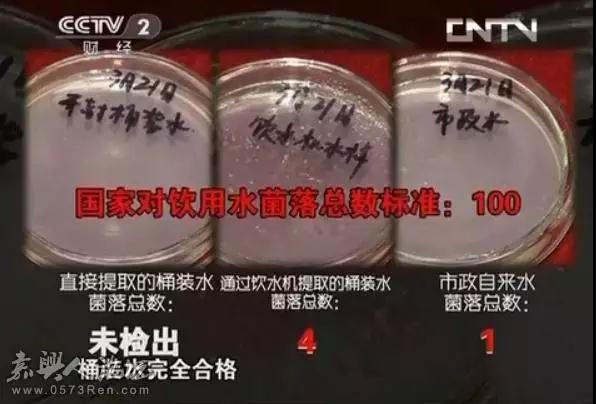

央視《是真的嗎?》做了一期關(guān)于桶裝水開(kāi)封三天的試驗(yàn),桶裝水,從開(kāi)封那一刻開(kāi)始,細(xì)菌就開(kāi)始滋生,知道3天后,細(xì)菌超過(guò)227倍,成了典型的的危險(xiǎn)水,是真的嗎?
網(wǎng)上有傳言稱,桶裝礦泉水開(kāi)封3天后,比自來(lái)水里的細(xì)菌還要多得多,這是真的嗎? 有媒體與醫(yī)院人士進(jìn)行了相關(guān)測(cè)驗(yàn),不測(cè)不知道,一測(cè)嚇一跳!
水樣調(diào)?。?br />
1、直接提取的桶裝水
2、通過(guò)飲水機(jī)提取的桶裝水
3、市政自來(lái)水

48小時(shí)過(guò)后,得到如下檢測(cè)結(jié)果:


1、 三天后,對(duì)同樣的桶裝水樣進(jìn)行檢測(cè),從飲水機(jī)提取的桶裝水檢測(cè)結(jié)果如下:
2、三天后, 對(duì)同樣的桶裝水樣進(jìn)行檢測(cè),直接提取桶裝水,不經(jīng)過(guò)飲水機(jī)檢測(cè)結(jié)果如下:
總結(jié):同樣是三天后,直接提取的桶裝水與從飲水機(jī)提取的桶裝水,細(xì)菌總數(shù)相差很大! 可見(jiàn)飲水機(jī)才是繁殖細(xì)菌的最大元兇!

專家建議:在日常使用過(guò)程中,最好對(duì)飲水機(jī)進(jìn)行清洗消毒,并且在選擇時(shí)最好能選擇三天后能飲用完的小容量產(chǎn)品。
通過(guò)飲水機(jī)提取開(kāi)封三天后的桶裝水前,將飲水機(jī)調(diào)到加熱狀態(tài),在飲水機(jī)加熱到最高溫度后,從熱水口接出另一瓶水樣,待冷卻后進(jìn)行檢測(cè),檢測(cè)結(jié)果表明:同樣是開(kāi)封三天后的桶裝水,經(jīng)加熱后未檢出菌落!

【檢測(cè)總結(jié)】
1、如果按日常飲用方式,通過(guò)飲水機(jī)接出的桶裝水,開(kāi)封三天后的細(xì)菌含量比開(kāi)封當(dāng)天連翻227倍!甚至遠(yuǎn)遠(yuǎn)超過(guò)國(guó)家對(duì)飲用水細(xì)菌總量的標(biāo)準(zhǔn); 但若對(duì)其加熱燒開(kāi),細(xì)菌就會(huì)被全部殺死,再次回到安全飲用狀態(tài)。
2、即使排除飲水機(jī)的污染,直接測(cè)量桶裝水本身,開(kāi)封三天后,細(xì)菌含量仍然超過(guò)市政自來(lái)水的菌落總量!
所以,桶裝水開(kāi)封三天,細(xì)菌含量遠(yuǎn)高于自來(lái)水,是真的?。?br />
作為家庭用水安全,就目前水質(zhì)而言,還是凈水器,可以解決你的后顧之憂,更安全、更健康!看到以上這些,您的心頭會(huì)微微一震嗎?甚至有些猶豫?是不是真的該買一臺(tái)凈水器了?值得你做決定。
凈水器的基本作用:出去中水的雜質(zhì)污染物,還原水的本質(zhì),無(wú)色無(wú)味干凈安全,所以養(yǎng)生前看看你家的水干凈嗎?
買個(gè)空調(diào)三千多,每年最多用三個(gè)月, 買個(gè)洗衣機(jī)四千多,每天最多洗一次,買個(gè)液晶電視五千多,每天最多看二小時(shí),買臺(tái)凈水器二千多,二十四小時(shí)關(guān)注您全家人的健康生活?請(qǐng)問(wèn)哪個(gè)重要?
為健康買單比什么都值得!民以食為天,食以水為先,水以凈為源!家里裝一臺(tái)凈水機(jī)就等于給家人安了一個(gè)體外“腎”!
有人替你開(kāi)車,替你賺錢,但是沒(méi)人替你生病,安裝凈水器已迫在眉睫。一組驚人的數(shù)據(jù)告訴你,我們喝的是怎樣的水。
由于水質(zhì)污染,全世界每年有5000萬(wàn)兒童死亡,3500萬(wàn)人患心血管病,7000萬(wàn)人患結(jié)石病,9000萬(wàn)人患肝炎,3000萬(wàn)人死于肝癌和胃癌。因水質(zhì)污染引起的新發(fā)病種越來(lái)越多,飲用水污染已成為最主要的水環(huán)境問(wèn)題。
一件衣服值1000元,小票能證明。一輛小車值50萬(wàn),發(fā)票能證明。一棟房子值500萬(wàn),房產(chǎn)證能證明。一個(gè)人到底值多少錢,唯有健康可以證明。健康是您的保障。所以請(qǐng)不要拿計(jì)算器計(jì)算您花在健康上的錢。有健康叫資產(chǎn),沒(méi)健康叫遺產(chǎn)!花個(gè)千把塊買個(gè)凈水器卻說(shuō)沒(méi)錢,難道健康還不如一個(gè)包,一輛車,一套房?
好多人說(shuō),等買了房子再買凈水器,我真不懂是你的房子需要喝好水,還是你需要喝好水?
它不是裝飾品,而是我們的細(xì)胞需要喝好水,細(xì)胞的80%都是水做的,健康的80%是水決定的!
健康不是看你有沒(méi)有錢,而是看你有沒(méi)有觀念! 健康不能等,房子幾十上百萬(wàn),凈水機(jī)不到1平米的錢,而且全家受益!